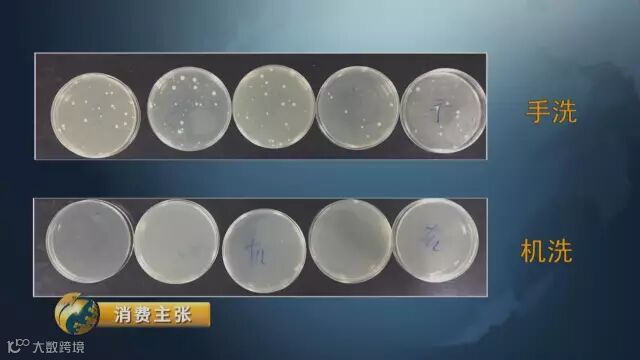

工作好忙,家务有点累,有什么办法可以“减负”?
买个洗碗机或许能帮到忙。不过,它是不是比手洗更费水?和中国洗碗机相比,外国洗碗机洗得更干净?
我们来看央视实验~~
洗碗机更费水吗?
把10位体验者分成两组,一组选择手洗,一组选择机洗。

体验开始前,准备两个一模一样的盛水塑料箱,分别把它们放置在手洗桌柜下面和机洗桌柜下面。如此可以看看,这两种洗碗方式分别会用掉多少水。

两组人面对的餐具数量都是一样的。餐具清洗完了,我们先来看看它们的用水情况。

左边这个是手洗完的,右面这个是机器洗的。二者比较,能明显看到右面塑料箱水量明显要低于左面塑料箱。
看来,机器洗碗非但不费水,反倒比人工洗要更省水!
看上去干净就真的干净吗?
虽然机器洗碗要更省水,但手洗组的人不大服气,他们认为,从结果来看,这两组餐具也差不多啊,看上去不是都挺干净吗?

餐具真像看上去那么干净吗?
青岛市疾病控制中心的两名工作人员把现场餐具取样,在她们的帮助下,可以对这两种餐具进行深度检测。
在日常生活中,很多人都以为餐具表面看上去干净就行了,但其实真相并非如此!
青岛市疾病控制中心消毒检验科主任权力敏表示,手洗由于细菌的滋生再加上洗洁精、洗碗布,污染率还是比较高的。碗筷消毒国标有要求,肠道菌不得检测出,致病菌不得检测出,细菌总数要小于100。这样来看,手洗完全超过标准,机洗完全符合标准。
外国洗碗机洗得更干净?
洗碗机的种类很多,嵌入式、驻立式、台式、还有水槽式,价格从2、3千元到1万多元不等。不少消费者都表示,买洗碗机,自己不知道该如何挑选。
外国产品跟中国产品会有多大差别?洗碗机也会挑餐具吗?
岳京松
中国家用电器研究院洗涤性能实验室主任,他也是相关国家标准的制定者。
这次记者跟随岳主任一起,对不同国家的洗碗机洗涤效果展开测试。
实验室里准备了10台洗碗机,涵盖了嵌入式、驻立式以及台式的中外不同品牌产品。准备洗涤的餐具分为国际标准的餐具和中国常见的餐具。餐具污染之后试验人员把它们分别放进这10台洗碗机里进行清洗。

岳京松指出:实验结果已经出来了,用电、用水没有太大差异,洗净和干燥(方面),国内样机表现比所选的国外样机要稍好,大概好2到3个百分点。
参与测试的一台外国产品,售价在4500元,跟它容量接近的两台中国产品价格都在3500元左右。从测试结果,这台外国产品洗净性能指数为1.08,而两台中国产品洗净性能指数一台是1.06,一台是1.14。也就是说,中国产品在清洗效果上,已经做得非常好。

岳京松表示,虽然洗碗机发源地在国外,但是经过多年研发,国内产品现在各方面已经不输于国外品牌,并且在适应性上还要更占优势。
对于饭粒这种污染物,国外产品的清洗效果就不尽如人意,主要是由于它的碗篮设计,没有专门针对中国碗的摆放设计,达不到理想的清洗效果。
碗篮,这是很多人都容易忽视的地方。岳主任介绍,中国人用的餐具有其独特性。相对来说,外国洗碗机保留了对欧式餐具的设计特点,所以在放入中国餐具时经常会发生尴尬情况。


如果我们把碗型餐具拿到欧式碗篮中,大家可以看到有一部分很难冲刷到。另外,比较大的中式大碗,在这种没有针对中式餐具专业性设计的碗篮中,几乎没法有效摆放,导致碗足部分残留污染物,叠放时候,碗足部分就会二次污染碗的内壁。


经过一番测试,央视《消费主张》得出这样的结论——
在清洁效果上,洗碗机确实要远远超过手洗,并且还能达到接近百分之百的除菌率。洗碗机虽然起初来自国外,但在除菌方面,反倒是我们中国人的独特发明创造,为全世界的洗碗机带来一场变革。
在费不费水这个问题上,中国家用电器研究院专门做过研究,结果发现洗碗机非但不费水,反倒比我们手洗更省水!因为洗碗机进水后,采用的是循环冲刷的方式清洁餐具,既能达到非常好的清洗效果,也避免了水资源浪费。
经过一番比较测试,发现中国的洗碗机产品更适合中国消费者。如果有意购买洗碗机,完全没必要去迷信外国品牌。
来源:广东质监

